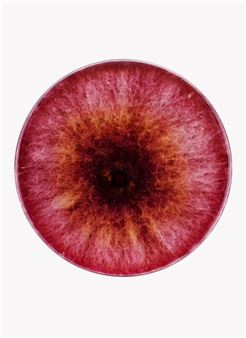
Nicolai Howalt: F.U.N.G.I.

Alexander Tovborg: Divine Comedy
ARoS presents Danish contemporary artist Alexander Tovborg's largest museum exhibition to date. In the exhibition Divine Comedy, Tovborg explores questions of morality and faith and opens up new interpretations of our shared narratives and mythological heritage.
Divine Comedy includes his largest and most ambitious paintings to date, including a monumental altarpiece altars of humanity (2017) and the extraordinary work The Knight of Faith (2016); Noah's Ark as an inflatable installation in bright colours, complete as a ship with roof and animals in pairs.
For the exhibition, Tovborg will create two site-specific works: A fresco-inspired mural with the apple as its symbolic focal point, painted directly on the museum's walls in the open atrium on Level 1, and a monumental mosaic on ARoS' windows, inspired by the colourful glass mosaics that often adorn churches.

Recommended for you
ARoS presents Danish contemporary artist Alexander Tovborg's largest museum exhibition to date. In the exhibition Divine Comedy, Tovborg explores questions of morality and faith and opens up new interpretations of our shared narratives and mythological heritage.
Divine Comedy includes his largest and most ambitious paintings to date, including a monumental altarpiece altars of humanity (2017) and the extraordinary work The Knight of Faith (2016); Noah's Ark as an inflatable installation in bright colours, complete as a ship with roof and animals in pairs.
For the exhibition, Tovborg will create two site-specific works: A fresco-inspired mural with the apple as its symbolic focal point, painted directly on the museum's walls in the open atrium on Level 1, and a monumental mosaic on ARoS' windows, inspired by the colourful glass mosaics that often adorn churches.
Artists on show
Contact details


 ARTISTS
ARTISTS